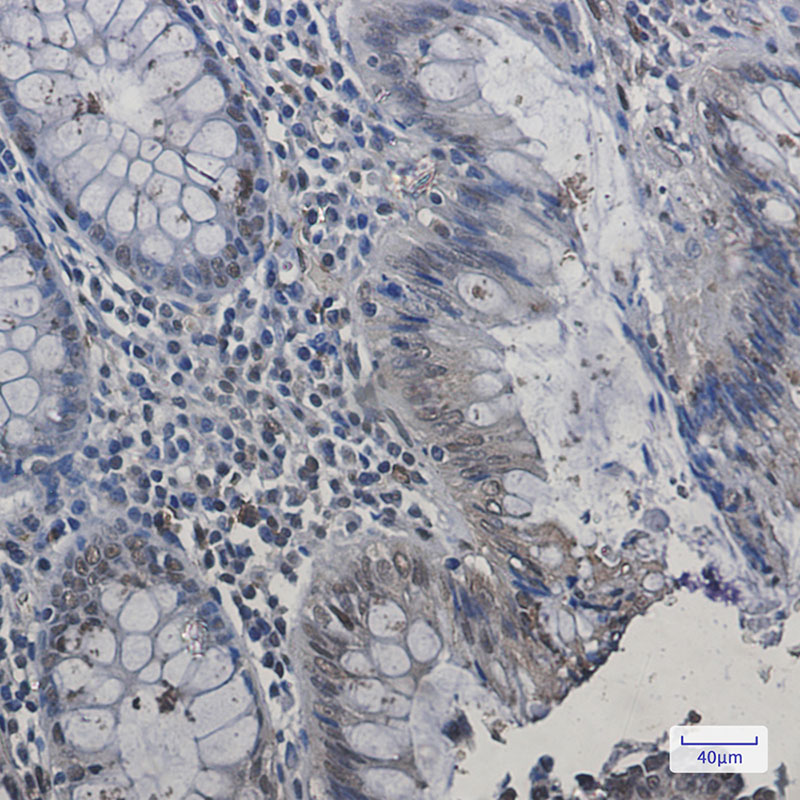

-
分类: 科研抗体货号: P21495别名: H2A.X; H2AFX; H2a/x; HIST5-2AX; Histone H2A.X应用: WB,IP,IHC,IF反应种属: Human,Mouse,Rat
-
分类: 科研抗体货号: P21504别名: HIP116; HIP116A; HLTF 1; Hltf; HLTF1; p113; RNF80; SMARC A3; SMARCA 3; SMARCA3; SNF2L3; ZBU1应用: WB,IF反应种属: Human
-
分类: 科研抗体货号: P21494别名: Histone H2A.2应用: WB反应种属: Human,Rat
-
分类: 科研抗体货号: P21503别名: MHC; HLAC; HLC-C; D6S204; PSORS1; HLA-JY3应用: WB,IP反应种属: Human,Mouse
-
分类: 科研抗体货号: P21493别名: Histone H1c; Histone H1s-2应用: WB,IHC,IF反应种属: Human,Mouse,Rat
-
分类: 科研抗体货号: P21502别名: Aw-68; HLA class I histocompatibility antigen; A-28 alpha chain; MHC class I antigen A*68; HLA-A; MHC class I antigen HLA A heavy chain应用: WB,IP,IHC,IF反应种属: Human
-
分类: 科研抗体货号: P21492别名: H1.a; H1F2; H1s-1; HIST1H1C; Histone H1.2; Histone H1c; Histone H1d; Histone H1s-1应用: WB,IHC,IF反应种属: Human,Mouse,Rat
-
分类: 科研抗体货号: P21501别名: Histone H4应用: WB,IHC,IF反应种属: Human
-
分类: 科研抗体货号: P21491别名: Histone H1.0; Histone H1(0); Histone H1.0; N-terminally processed; H1F0; H1FV; Histone H5应用: WB,IHC反应种属: Human,Rat,Hamster
-
分类: 科研抗体货号: P21521别名: CBX5; HP1A; Chromobox protein homolog 5; Antigen p25; Heterochromatin protein 1 homolog alpha; HP1 alpha应用: WB,IP,IHC,IF反应种属: Human,Mouse,Rat

鄂公网安备42018502007531号
鄂公网安备42018502007531号

